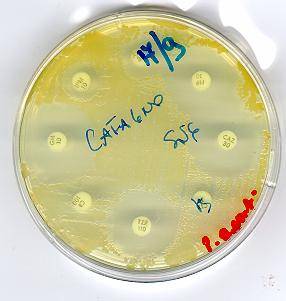

Microorganismi
I microorganismi sono coltivati sugli
appositi terreni e mantenuti in coltura pura. Molte specie batteriche possono
essere conservate a lungo in agar germi (50% agar 50% sospensione batterica in
brodo) a temperatura ambiente, in recipiente chiuso ermeticamente senza perdere
vitalità. In particolare Enterobacteriaceae, Pseudomonas, Stafilococchi
e enterocochi, tuttavia la refrigerazione può essere il sistema più sicuro.
Dall'isolamento su piastra si raccolgono diverse colonie e si fa una sospensione
densa in BH (Brain-Heart) brodo, si aggiunge quindi glicerolo 15-20% finale e
si conserva a -80°C.
Se si dispone del solo frigorifero a -20°C è sufficiente ricordare che il
mantenimento della vitalità si riduce nel tempo. Per rivitalizzare i microorganismi
si immerge l'ansa rovente nel glicerolo senza scongelare il contenitore e il
poco raccolto si semina su piastra. Per i batteri mantenuti in agar germi si
trasferisce un'ansata del contenitore su piastra.
I microorganismi di controllo vanno
sempre saggiati insieme ai patogeni dello studio.
Antibiotici
Le soluzioni madri degli antibiotici
vanno preparate nel solvente indicato dal produttore e alla concentrazione di
1000 µg/ml. E' necessario controllare la potenza del farmaco che in genere è
riportata sul contenitore. I b-lattamici una volta posti in soluzione vanno usati entro la giornata,
a volte si può congelare la soluzione e risciolta quando necessario, conviene
sempre controllare la qualità del farmaco con i microorganismi di riferimento.
Gli altri antibiotici non pongono problemi di stabilità specie se conservati e
disciolti come suggerito dal produttore.
Figura 1. Rappresentazione schematica
di un antibiogramma.